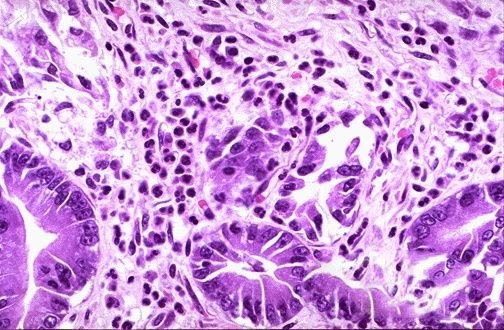

(一)发病原因
1.结肠的血管解剖和生理 结直肠血供主要来源于肠系膜上、下动脉和髂内动脉。右半结肠的动脉来自肠系膜上动脉,左半结肠和直肠上部来自肠系膜下动脉,直肠中下部的动脉血则来自髂内动脉。
(1)肠系膜上动脉:起源于约第1腰椎平面的腹主动脉前壁,位于腹腔动脉起点下方1.0~1.5cm处。该动脉由胰腺颈部下缘穿出,纵行跨过十二直肠横部,进入小肠系膜根部,然后分出结肠中动脉、右结肠动脉和回结肠动脉,分别提供近侧横结肠、升结肠和回盲部的血供。
结肠中动脉在胰腺下缘起自肠系膜上动脉,在胃后进入横结肠系膜内,分为左右两支。在横结肠肝曲附近与右结肠动脉的升支吻合;在脾曲附近通过Riolan吻合支与左结肠动脉升支吻合,该部位的吻合支比较细小。另外约有5%的人群缺如,使之成为结肠血供的最薄弱处,容易发生缺血性损害。在正常人群中,大约有20%的人结肠中动脉缺如或发育不良。
右结肠动脉在结肠中动脉起点下方1~3cm处起于肠系膜上动脉,经腹膜后向右横行,至升结肠附近分为升支和降支,分别与结肠中动脉右支和回结肠动脉结肠支吻合,形成结肠的边缘血管弓,并沿途分支至升结肠供应升结肠。
回结肠动脉在右结肠动脉起点下方起源于肠系膜上动脉,有时与右结肠动脉合成一条主干,经腹膜后向右下方斜行,至盲肠附近分为上下两支,升支与右结肠动脉降支吻合,降支到回盲部分成两支与肠系膜上动脉的回肠支吻合,供给升结肠下段、回盲部和回肠末段的血供。
(2)肠系膜下动脉:在第3腰椎,十二指肠水平部下方3~5cm起源于腹主动脉前壁,呈弓状斜向左下方,行进2~7cm后,相继分出左结肠动脉和乙状结肠动脉,并跨越左侧髂总动脉,移行为直肠上动脉。
左结肠动脉从距肠系膜下动脉根部2.5~3.5cm处分出,经腹膜后向左上和左下方分出升支和降支,升支在脾曲与结肠中动脉的左支吻合,降支与乙状结肠动脉吻合,分别提供横结肠远侧和降结肠的血供。
乙状结肠动脉的起点变化较大,人群中约36%直接起源于肠系膜下动脉,30%起源于左结肠动脉,数目也有较大差别,一般为2~6条。乙状结肠动脉经腹膜深面斜向左下方进入乙状结肠系膜内,互相吻合,构成动脉血管弓和边缘动脉。上部动脉与左结肠动脉的降支形成吻合支,供给降结肠远侧的血供。在最下部与直肠上动脉之间没有边缘动脉连接,成为结肠血供的另一个薄弱点,又称Sudek点,容易发生缺血性病变。
直肠上动脉起自最下支乙状结肠动脉的下方,在第2骶椎水平的直肠后面,分为左、右两支,供给大部分直肠的血供。
下部直肠的血供主要由发自髂内动脉的直肠中动脉和直肠下动脉供给。
(3)边缘动脉:各结肠动脉在肠壁附近相互吻合,形成多个与结肠壁平行走向的连续性动脉弓称为边缘动脉,又称Drummond血管弓。边缘动脉由回盲部分布至直肠乙状结肠连接处,由单一动脉连接或由1、2级动脉弓连接,并从最靠近肠壁的血管弓上发出小的终末血管分布到肠壁。
这些血管弓具有重要的临床意义,在大多数情况下,他们在不同的水平上构成了各个结肠动脉之间的交通。当某一结肠动脉的主干发生阻塞时,其供血区域内的结肠可以通过该血管弓由其他动脉主干得到血液供给,不至于发生缺血。但是,如果阻塞发生于该血管弓的最靠近肠壁的部位,供应肠壁的终末动脉就难以通过侧支循环得到血供。
(4)终末动脉:是由边缘动脉向肠壁发出的长短不等的小动脉,与结肠成垂直方向,负责直接向肠壁供血。终末动脉有长支和短支2种,长支从边缘动脉分出后在肠壁的系膜缘处分为前后2支,经浆膜和肌层之间至肠壁的游离缘,供应对系膜缘1/3肠管的血供。这两支终末动脉在肠管的系膜缘和对系膜缘处的吻合较少,使得结肠对系膜缘部位的血供容易发生障碍;短支起于边缘动脉或终末动脉的长支,在近系膜缘处穿入肠壁,供应系膜缘2/3的肠管。终末动脉的发育和分布在左半结肠较为密集;右半结肠比较稀少,而且自边缘动脉至肠壁的距离也较长。这些终末动脉对血管收缩剂非常敏感,相互之间侧支循环很少。由于上述原因,当发生较长时间的血管收缩时,肠壁就难以得到充足的血供,容易发生缺血,这在右半结肠更为明显。
结直肠壁的全层均有血管丛,但黏膜和黏膜下层的血管丛最为丰富,供应黏膜腺体的血管来源于黏膜下血管丛。当休克或低血压引起终末动脉的血流减少时,肠壁内就会出现动静脉分流,使黏膜发生缺血。缺血的程度取决于肠壁的侧支循环和血管阻塞的部位,在较大结肠动脉的根部发生血管阻塞时,通过边缘血管弓的侧支循环,相关区域内的结肠不一定发生缺血,但如果同时伴有边缘血管弓的发育异常,其供血区就会发生节段性肠缺血,甚至坏死。而动脉阻塞愈靠近肠壁,愈容易引起肠壁的血供障碍,有人报道一个长支血管的损伤可以使肠管坏死约2.5cm。
(5)静脉:结肠壁内静脉丛汇集成小静脉,在肠系膜缘处合成为较大静脉,与结肠动脉并行,成为与结肠动脉相应伴行的静脉。结肠中静脉、右结肠静脉和回结肠静脉合成肠系膜上静脉,进入门静脉。乙状结肠静脉、左结肠静脉和直肠上静脉合成肠系膜下静脉,在肠系膜下动脉外侧向上,到十二指肠空肠曲外侧,经胰腺后方进入脾静脉,最后入门静脉。
2.病因和发病机制 引起结肠缺血有很多原因,大体可分为2大类,一类为血管阻塞型,另一类为非血管阻塞型。
(1)血管阻塞型结肠缺血:在血管阻塞型结肠缺血中,比较常见的原因有肠系膜动脉的创伤、肠系膜血管血栓形成或栓塞,以及腹主动脉重建手术或结肠手术时结扎肠系膜下动脉。
腹部钝性伤时,如果肠系膜血管受到损伤和有血栓形成或腹膜后血肿形成,都有可能引起结肠缺血,患者常伴有广泛的内脏、躯体四肢、心肺和神经系统损伤。Dauterive等报道870例腹部钝性伤手术病人中,41例伴有肠道缺血性病变。
腹主动脉造影可诱发肠系膜动脉内的血栓形成,引起缺血性肠炎,但发生率比较低。其原因可能是由于造影剂对血管内壁的刺激或者检查时由于导管对血管的损伤而引起。
动脉粥样硬化的脱落物,或来自房颤病人的左心房栓子,也可以引起肠系膜动脉的阻塞。如果仅仅是肠系膜下动脉阻塞,而不伴有侧支循环障碍、进行性栓子脱落以及肠系膜上动脉根部的阻塞,则由于有边缘血管弓的存在,受累部位结肠可以通过侧支循环得到血供,一般不会发生结肠缺血。如果患者结肠血管弓先天性发育不良或双侧髂内动脉有阻塞,则单纯的肠系膜下动脉阻塞也可以引起结肠的梗塞。Williams报道称疾病的严重程度和生存率与肠系膜下动脉的梗阻情况没有直接关系,梗阻组的生存率为65%,非梗阻组为60%。因而单纯大动脉的是否梗阻似乎并不影响该病的临床表现和预后。
近年来,伴发于腹主动脉手术后的缺血性结肠炎已越来越引起人们的重视,Bjorck等对415例腹主动脉手术患者进行随访,发现缺血性结肠炎的发生率为2.6%。如果手术过程中发生过休克,发生率可达7.3%。急诊手术后的发生率明显高于择期手术。其发生一方面与术中在根部结扎肠系膜下动脉有关,另一方面可能还与其他一些因素有关,例如患者髂内动脉的开放程度,术中主动脉的断血时间,肠系膜下动脉的结扎部位,结肠血管弓的开放程度,动脉硬化程度,低血压的时间,心功能状况以及是否伴有小血管病变等。
比肠系膜下动脉根部阻塞更为重要的是周围小动脉的梗阻,尤其在年轻患者。引起小动脉阻塞的原因很多,包括糖尿病、血管炎、全身胶原性疾病,尤其是系统性红斑狼疮,以及结节性多发性动脉炎、过敏性肉芽肿病、Behcet综合征、Buerger病、应用某些药物等。再生障碍性贫血、镰形细胞疾病、淋巴瘤、白血病以及肿瘤化疗也可以引起缺血性肠炎。
静脉回流受阻和静脉血栓形成引起的结肠缺血常发生于右半结肠,研究显示,静脉阻塞可以引起肠壁的水肿、梗死和纤维化。常见的原因有门脉高压、胰腺炎伴发胰腺脓肿和胰腺假性囊肿,以及长期口服避孕药等。胰腺炎伴发结肠坏死的病死率可达50%左右。
结肠壁血供会受肠道直径、肠壁内肌肉张力和肠腔内压力的影响。Saegesser报道随着肠腔内压力升高,肠壁内血流减少,肠壁内动静脉氧含量差别也减少。此时,肠黏膜缺血程度比浆膜层更为明显。结肠扩张引起结肠缺血,而结肠缺血又会进一步导致结肠扩张,从而形成恶性循环。在肠梗阻时,如果回盲瓣功能良好,几乎所有的盲肠穿孔都是由于肠壁缺血、坏死引起。除梗阻时间、梗阻部位、回盲瓣关闭功能以及肠道扩张的程度等的影响以外,各种原因引起的组织灌流不足,如休克、脱水、酸中毒、心肌功能衰竭等也可以加重由于结肠梗阻引起的肠缺血。
(2)非血管阻塞型结肠缺血:大多为自发性,通常不伴有明显的血管阻塞,临床上难以找到明确的引发结肠缺血的原因。其中大部分患者为老年人,在发生结肠缺血性改变后,肠系膜血管造影显示的血管异常可与临床症状不相符。
有多种原因可以诱发自发性结肠缺血,其中各种原因引起的低血压最为常见,如感染性休克、心源性休克、过敏性休克、神经性休克等,同时伴有心脏病、高血压、糖尿病以及同时服用可影响内脏血流的药物(如升压药等),可以明显增加结肠缺血的发生机会。肠系膜血供减少,引起结肠缺血;而大范围急性肠系膜血供障碍又可引起明显的不可逆性心输出量减少,因而导致肠系膜缺血的恶性循环。
(二)发病机制
1.病理分类 缺血性结肠炎按病因可分为血管阻塞和非坏疽型2种,其中非坏疽型又可分为一过性可逆型和慢性不可逆型
2.好发部位 缺血性结肠炎可以发生于检查的任何部位,但是靠肠系膜下动脉供血的左半结肠发生率最高。Saegesser报道112例,其中37例病变位于降结肠,33例位于结肠脾曲,24例位于乙状结肠。终末动脉分布较少的右半结肠也是比较常见的好发部位。个别患者病变可以累及全结肠。病变发生部位与缺血原因也有一定的联系,继发于全身低血压的缺血性病变多发生于右半结肠,尤其是结肠的后壁,而伴发于腹主动脉手术后的患者,病变多位于左半结肠。
3.病理变化
(1)可逆型结肠缺血:大多仅累及黏膜和黏膜下层,病变比较轻,没有明显的组织坏死。肉眼可见肠壁变厚,黏膜水肿,呈鹅卵石样变化,同时伴有黏膜的线形溃疡和出血。重症患者则可见明显的黏膜溃疡,但黏膜肌层很少有缺血性改变,浆膜层正常。部分患者在组织修复前可有黏膜的脱落。
典型的组织学表现为黏膜下层慢性炎性细胞浸润和肉芽组织形成。于广泛存在的溃疡之间可见散在存活的黏膜岛,在黏膜脱落部位的黏膜床可见到肉芽组织和炎性细胞,有时在黏膜下动脉中可见到小动脉炎和纤维蛋白栓子。在上皮再生的部位可见到毛细血管增生、成纤维细胞和巨噬细胞。肉芽组织周围可有嗜酸性粒细胞和含血红蛋白铁的组织细胞浸润,这些含血红蛋白铁的巨噬细胞的存在提示以前有出血性肠梗死的发生,可用于与溃疡性结肠炎和克罗恩病鉴别。另外,在缺血性结肠炎,约80%的黏膜固有层呈透明样变性,依此可以与假膜性肠炎鉴别。
(2)坏疽型:典型的病理表现是在病变部位可见到程度不等的组织坏死。在轻症患者,可见肠腔扩张,黏膜出血,肠壁脆弱变薄,并可见深度和范围不等的黏膜溃疡和坏死,肠腔内充满血液。肉眼观病理变化类似暴发型溃疡性结肠炎。在血管再生期,肠壁变厚,如果肠壁全层发生缺血性改变则可引起肠腔狭窄。如果缺血较轻,可以仅有黏膜的病理变化,而浆膜层正常。在重症患者,肠壁呈黑色或绿色,肠壁组织溶解变薄,肠黏膜脱落,肌层显露,部分患者肌层坏死脱落,肠壁发生穿孔。
组织学检查可见黏膜和黏膜下层出血、水肿。肠腺的表层部分最早出现变化,腺管内充满炎性细胞和红细胞,黏膜表面有纤维蛋白和坏死组织沉积,与假膜性肠炎的病理变化有时难以区别。早期病变有大量炎性细胞浸润,随后黏膜脱落,形成不规则的坏死性溃疡。在黏膜和黏膜下层的毛细血管内可见到典型的纤维蛋白栓子。革兰染色可见黏膜下有细菌侵入。在严重缺血性肠炎的患者,正常组织已极少残存,仅有坏死的黏膜肌层和黏膜下层组织显露。
(3)慢性狭窄型:组织结构在慢性炎症过程中由纤维组织取代,在局部形成管状狭窄。狭窄造成的梗阻一般为非完全性的,距离比较短,在乙状结肠最为常见。该狭窄段与憩室病和克罗恩病引起的狭窄难以鉴别。组织学检查的典型表现为环形的黏膜消失,溃疡区域由肉芽组织和新生的毛细血管覆盖。溃疡的边缘伴有上皮的再生,黏膜肌层扭曲并伴有广泛的纤维化。黏膜下充满肉芽组织、成纤维细胞、浆细胞、嗜酸性细胞以及慢性炎性细胞。肠壁浆膜面和结肠周围脂肪内可见散在的炎性变化。